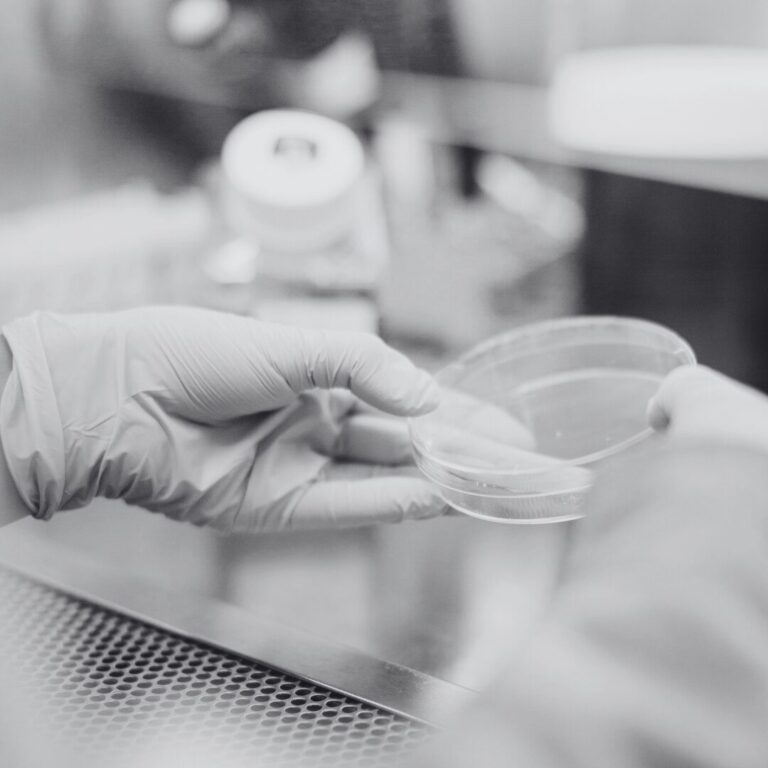

Articles
Filter
Individuals with addictive disorders frequently have medical and (underlying) psychiatric comorbid conditions and high disease burden
This article reviews the body-first and brain-first model of Lewy body disease (BvB model), a theoretical framework that synthesises findings from clinical studies, epidemiology, animal models, and postmortem studies.
Migraine is a prevalent neurological disorder characterized by recurrent and disabling attacks of moderate to severe headache
Stem Cell Exosomes have the potential for the treatment of brain diseases such as autism spectrum disorder (ASD).
This article summarizes the use of virtual reality in the treatment of severe mental illnesses with the example of psychosis.
Alzheimer’s disease (AD) is the most prevalent neurodegenerative disease and the leading cause of dementia worldwide, regardless of socioeconomic status.
No results matched your search.
Please try again.